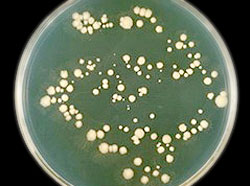

Niežulys, perštėjimas, deginimo jausmas, paraudimas ir patinimas pačioje intymiausioje moters kūno dalyje, ar gali būti dar kas nemaloniau? Trys iš keturių moterų bent kartą patiria šį nemalonų pojūtį, kurio vardas – makšties kandidozė arba pienligė. Kokia tai liga ir kaip ją įveikti, kalbiname gydytoją ginekologę doc. dr. Mariją Butylkiną.
Niežulys, perštėjimas, deginimo jausmas, paraudimas ir patinimas pačioje intymiausioje moters kūno dalyje, ar gali būti dar kas nemaloniau? Trys iš keturių moterų bent kartą patiria šį nemalonų pojūtį, kurio vardas – makšties kandidozė arba pienligė. Kokia tai liga ir kaip ją įveikti, kalbiname gydytoją ginekologę doc. dr. Mariją Butylkiną.
Kodėl sergame makšties kandidoze?
Išorinių lytinių organų ir makšties kandidozė, dažnai vadinama pienlige, sukelia baltasis balšvagrybis (Candida albicans), plačiai paplitęs aplinkoje, kai kuriuose maisto produktuose, dirvožemyje ir net sveiko žmogaus organizme. Nepažeista moters makšties gleivinė veikia antimikrobiškai, todėl patekęs nedidelis Candida grybelių kiekis nesidaugina, neišplinta ir nesukelia jokių požymių. Tačiau pakitus hormonų balansui, susilpnėjus organizmo imunitetui, sutrikus natūraliai makšties bakterinei florai, atsiranda palankios sąlygos vystytis grybelinei infekcijai.
Kokio amžiaus moterys dažniausiai serga pienlige?
Pienligė – įvairaus amžiaus moterų liga. Tačiau menopauzės metu, sumažėjus estrogenams, makšties sienelė tampa plona, sausa ir lengvai pažeidžiama. Todėl susidaro palanki terpė vystytis makšties grybeliui.
Kodėl daugelis moterų pirmą kartą su kandidoze susiduria nėštumo metu?
Nėštumo metu pakinta hormonų santykis bei padidėja glikogeno koncentracija makštyje, tokiu būdu sukuriama puiki terpė Candida grybeliams daugintis.
Kodėl cukriniu diabetu sergančių moterų pienligė neaplenkia?
Kodėl cukriniu diabetu sergančių moterų pienligė neaplenkia?
Pienligė tarpsta susilpnėjus organizmo imunitetui. O jį silpnina ne tik cukrinis diabetas, bet ir kitos lėtinės ligos, operacijos, kai kurie vaistai, netinkamai subalansuota mityba, vitaminų trūkumas.
Ar galima užsikrėsti pienlige lytiniu keliu?
Nors vulvos ir makšties kandidozė nepriklauso lytiškai plintančioms ligoms, tai yra infekcinė liga, tačiau lytinis konktaktas su Candida grybelį nešiojančiu partneriu yra vienas iš galimų užsikrėtimo būdų. Vyrai pienlige neserga, tačiau yra jos besimptomiai nešiotojai. Jei moteriai dažnai kartojasi pienligė, tada būtina gydyti ir partnerį.
Kokie pagrindiniai simptomai padeda atpažinti pienligę?
Pienligę galima įtarti esant šiems simptomams:
- gausios, varškės konsistencijos išskyros;
- stiprus išorinių lytinių organų niežėjimas, perštėjimas ar deginimas, taip pat tarpvietės paraudimas ar patinimas;
- skausmingas šlapinimasis;
- negausus kraujavimas iš makšties gleivinėje susidariusių žaizdelių
Kodėl po antibiotikų vartojimo dažnai susergama pienlige?
Vartojant plataus veikimo spektro antibiotikus, užslopinama natūrali makšties bakterinė flora. Tuomet ir atsiranda palankios sąlygos daugintis Candida grybeliams.
Ar turi įtakos pienligei moters intymios higienos įpročiai?
Išorinius lytinius organus reikėtų prausti tik intymiai higienai skirtomis priemonėmis, kurios nesutrikdytų pH pusiausvyros. Todėl savo pacientėms patariu rinktis intymios higienos prausiklius su natūraliais vaistažolių ekstraktais bei pieno rūgštimi. Priemonės turėtų būti be agresyvių ir kenksmingų sveikatai dirgiklių.
Kodėl menstruacijų metu pienligės simptomai paūmėja?
Menstruacinės išskyros bei imuniteto nusilpimas mėnesinių metu sudaro labai palankią aplinką grybelių dauginimuisi. Todėl menstruacijų metu nerekomenduojama naudoti sintetinių, nelaidžių orui higieninių įklotų ir paketų – puiki alternatyva šioms priemonėms – vaistinėse parduodami „Lady ANION®” higieniniai paketai ir įklotai su ekologiška medvilne ir anijonine juostele.
Kaip gydoma makšties kandidozė?
 Makšties kandidozė yra gydoma vaistais nuo grybelinės infekcijos. Jie gali būti įvairių formų: geriamosios kapsulės/tabletės, makšties ovulės ar makšties kremas. Gali būti skiriamas vietinis, sisteminis arba kombinuotas pienligės gydymas priklausomai nuo ligos formos: ūmi ar lėtinė (pasikartojanti). Gydymo trukmė labai įvairi: nuo vienkartinės dozės iki 6 mėnesių kurso. Praktikoje savo pacientėms skiriu vietinio veikimo makšties ovules su boro rūgštimi „Flugenil® 600”. „Flugenil® 600” sudėtyje esanti boro rūgštis turi priešgrybelinių savybių ir yra saugi alternatyva nuolat atsinaujinantiems makšties uždegimo simptomams šalinti1. Vietiškai vartojama boro rūgštis į kraują beveik nepatenka, nebent yra labai pažeista makšties gleivinė2, todėl Kanados šeimos gydytojai rekomenduoja vartoti net ir nėštumo metu nuo antrojo trimestro 600mg boro rūgšties makšties ovules vieną kartą per dieną, 14 dienų3. Avižų ekstraktas padeda nuraminti sudirgusią, niežulio kamuojamą makštį. Hialurono rūgštis užtikrina ilgalaikį makšties gleivinės drėkinimą, o vitaminas E pagerina gleivinės epitelio atsistatymą.
Makšties kandidozė yra gydoma vaistais nuo grybelinės infekcijos. Jie gali būti įvairių formų: geriamosios kapsulės/tabletės, makšties ovulės ar makšties kremas. Gali būti skiriamas vietinis, sisteminis arba kombinuotas pienligės gydymas priklausomai nuo ligos formos: ūmi ar lėtinė (pasikartojanti). Gydymo trukmė labai įvairi: nuo vienkartinės dozės iki 6 mėnesių kurso. Praktikoje savo pacientėms skiriu vietinio veikimo makšties ovules su boro rūgštimi „Flugenil® 600”. „Flugenil® 600” sudėtyje esanti boro rūgštis turi priešgrybelinių savybių ir yra saugi alternatyva nuolat atsinaujinantiems makšties uždegimo simptomams šalinti1. Vietiškai vartojama boro rūgštis į kraują beveik nepatenka, nebent yra labai pažeista makšties gleivinė2, todėl Kanados šeimos gydytojai rekomenduoja vartoti net ir nėštumo metu nuo antrojo trimestro 600mg boro rūgšties makšties ovules vieną kartą per dieną, 14 dienų3. Avižų ekstraktas padeda nuraminti sudirgusią, niežulio kamuojamą makštį. Hialurono rūgštis užtikrina ilgalaikį makšties gleivinės drėkinimą, o vitaminas E pagerina gleivinės epitelio atsistatymą.
1 J Womens Health (Larchmt), 2011m., „Boric Acid Recurrent Vulvovaginal Candidiasis: The Clinical Evidence”.
2 Acs N, Banhidy F, Puho E, Czeizel AE. Soong D, Einarson A. Teratogenic effects of vaginal boric acid treatment during pregnancy. Int J Gynecol Obstet. 2006; 93(1):55-56.
3 Soong D, Einarson A. Vaginal yeast infections during pregnancy. Can Fam Physician. 2009; 55(3):255-6.


















